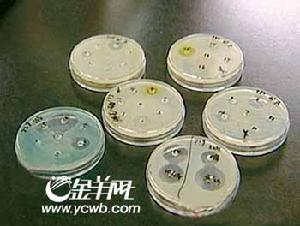
鞣酸小檗鹼

藥理及套用
 鞣酸小檗鹼
鞣酸小檗鹼在腸液中分解,產生游離的小檗鹼和鞣酸,起抗菌和收斂作用。適用於痢疾桿菌、大腸桿菌等引起的腸炎、痢疾。因無苦味,故易為患者所接受。
用法用量
口服,成人:一次1~3片,一日3次;兒童用量見下表:1-3歲,10-14公斤,一次0.5-1片,一日3次;4-6歲,16-20公斤,一次1-1.5片,一日3次;7-9歲,22-26公斤,一次1.5-2片,一日3次;10-12歲,28-32公斤,一次2-2.5片,一日3次。
不良反應
注意事項
 溶血性貧血
溶血性貧血2、妊娠期頭三個月慎用。
3、如服用過量出現嚴重不良反應,請立即就醫。
4、當藥品性狀發生改變時禁止使用。
5、兒童必須在成人監護下使用。
6、請將此藥放在兒童不能接觸的地方。
相互作用
1、含鞣質的中藥與黃連素合用後,由於鞣質是生物鹼的沉澱劑,二者結合,生成難溶性鞣酸鹽沉澱,降低療效。
2、如正在服用其他藥品,使用本品前請諮詢醫師或藥師。鞣酸鹽沉澱,降低療效。
副反應案例
病例簡介
患兒,女,4歲,因急性腹瀉於2004年12月3日來診。查體:T369℃,腹軟,腸鳴音亢進,大便常規提示急性細菌性腹瀉,給予鞣酸小檗鹼1片口服,3次/d。服藥1d後患兒排尿時大哭,詢問原因,患兒自述尿痛,觀察患兒排尿呈間斷性、尿滴瀝,排尿即痛,尿色黃濁。次日,患兒家長帶其就診,查尿常規正常,考慮尿痛現象與用藥有關,即停藥,改為對症輸液治療,當日晚患兒尿痛現象緩解。
討論
 膽
膽藥效學
 神經系統
神經系統鞣酸小檗鹼是一種重要的生物鹼,是中國套用很久的中藥。可從黃連、黃柏、三顆針等植物中提取。它具有顯著的抑菌作用。常用的鹽酸鞣酸小檗鹼又叫鹽酸小檗鹼。鞣酸小檗鹼能對抗病原微生物,對多種細菌如痢疾桿菌、結核桿菌、肺炎球菌、傷寒桿菌及白喉桿菌等都有抑制作用,其中對痢疾桿菌作用最強,常用來治療細菌性胃腸炎、痢疾等消化道疾病。臨床主要用於治療細菌性痢疾和腸胃炎,它無抗藥性和副作用。
用中醫學解釋,此類藥物性涼,能清除邪熱或虛熱,清除有害毒物,自古以來就是中醫手中的一味清熱解毒良藥。通常每次口服0.1~0.5克,每日三次。
藥物分析
 血液細胞
血液細胞在兩年多前,國家藥監局曾公布了一批停用的藥品,其中包括複方鞣酸小檗鹼片和複方鞣酸小檗鹼注射液,有媒體誤報鞣酸小檗鹼已停用,引起了很大的誤會。所謂的“複方鞣酸小檗鹼”,是按照地方標準生產的藥物,此次停用是因為“質量不可控”,該藥與我們常說的鞣酸小檗鹼是完全不同的藥物。鞣酸小檗鹼仍收錄於國家基本藥品目錄,使用非常安全。
雖然鞣酸小檗鹼是良藥,但不可亂用,應正確選用。首先,對於全身性感染疾病,不適宜選擇鞣酸小檗鹼,因為它口服吸收極差,幾乎停留在胃腸道,不易透過胃腸道進入血液,所以只適合胃腸消化道炎症性疾病。
其次,腹瀉的原因很多,總體可分感染性腹瀉,多呈急性腹瀉;非感染性腹瀉,多呈慢性腹瀉。由上面對鞣酸小檗鹼藥理作用的介紹可知,鞣酸小檗鹼只適用於感染性腹瀉。胃腸感染表現可輕可重,輕者僅腹痛、腹瀉,重者會有噁心、嘔吐、發熱寒戰、食欲不振,嚴重時導致脫水、酸中毒、休克。一般而言,對輕型炎症可以選用鞣酸小檗鹼,對於重型則必須合用抗感染作用強的抗生素。
而慢性非感染性腹瀉的病因複雜,腸易激綜合徵、潰瘍性結腸炎、營養不良、內分泌疾病、肝硬化、尿毒症、過敏性疾病、癌症等,都可以導致慢性腹瀉。對非感染性的腹瀉、腹痛,鞣酸小檗鹼是毫無作用的。像常見的過敏性蕁麻疹胃腸型,如果不採取解除過敏綜合治療,僅用鞣酸小檗鹼是控制不了腹瀉的。而腸易激綜合徵的患者,在吃2~3片鞣酸小檗鹼後,腹痛、腹瀉常常會消失,但這並非鞣酸小檗鹼的功勞。因為腸易激綜合徵是可自行緩解的疾病,但又是反覆發病難以根治的病症,其腹瀉症狀的消失,與吃鞣酸小檗鹼無關。
在日常生活中,有人為了避免腹瀉,在外出吃飯、游旅之時,提前吃上幾片鞣酸小檗鹼,這種做法並不妥當。因為這樣做,可以說是一種對細菌的“挑逗”行為,會讓細菌產生耐藥性。而且預防的劑量通常都不會太大,細菌在與藥物抵抗中容易“獲勝”。如果經常這樣“鍛鍊”細菌,只能使細菌“抵抗”經驗豐富,由弱變強,有害無益。
 試驗用鼠
試驗用鼠臨床套用前景
鞣酸小檗鹼常用於治療腸道細菌感染性疾病,隨著臨床上進一步的研究,近年來發現其對心律失常、高血壓、血小板聚集、糖尿病、高脂血症、消化性潰瘍、膽囊炎等疾病的治療均有滿意的療效,可供臨床用藥參考。
鞣酸小檗鹼(又名小檗鹼),是從中藥黃檗、黃連、三棵針、唐松草等植物的藥材中提取出來的生物鹼。臨床上套用的製劑多為鹽酸鞣酸小檗鹼,現能人工合成。由於鞣酸小檗鹼能使細菌表面的菌毛數量減少,使細菌不能附著在人體細胞上引起感染,因而具有抗感染作用,對革蘭陽性、陰性細菌均能抑制,故常用於治療痢疾桿菌、大腸桿菌、金葡菌等引起的腸道疾病和化膿性中耳炎。近年來,隨著研究的不斷深入,發現它還有其他用途,現報告如下
抗心律失常
 動態心電圖
動態心電圖抗高血壓
鞣酸小檗鹼抗高血壓的作用機制主要是競爭性阻斷血管平滑肌的α受體,使外周血管阻力降低;另外還可通過抗膽鹼酯酶活性而增強乙醯膽鹼作用,使血管擴張。對53例高血壓患者,在停用各種降壓藥1周后,以單盲法給予口服鞣酸小檗鹼0.4g,4次/d,療程4周。53例中Ⅰ期高血壓31例,Ⅱ期高血壓22例,結果用藥後3~5天血壓開始下降,6~9天平均收縮壓下降(27±14.25)mmHg,舒張壓下降(16.5±9.75)mmHg,總有效率達69.8%(P<0.01)。
對123例高血壓病患者隨機分為兩組,鞣酸小檗鹼為試驗組66例,複方羅布麻為對照組57例。試驗組:口服鞣酸小檗鹼0.2~0.5g,3次/d;對照組:口服複方羅布麻每次2片,3次/d,兩組均以28天為1個療程,試驗期間停用抗高血壓藥。結果:鞣酸小檗鹼組顯效29例,有效31例,無效6例,總有效率90.9%;複方羅布麻組顯效14例,有效30例,無效13例,總有效率77.2%,鞣酸小檗鹼顯著優於複方羅布麻(P<0.01)。
抗血小板聚集
對人類首次套用鞣酸小檗鹼治療血小板聚集率增高患者的研究,結果表明,對高聚集率患者,鞣酸小檗鹼有效地降低血小板聚集率,有效率為95%。套用本品與套用潘生丁合併阿司匹林有相似療效,其機制可能抑制血小板膜的α2受體使血小板cAMP升高,而使血栓烷A2(TXA2)含量降低。有學者認為,鞣酸小檗鹼可能成為新型抗血栓藥物用於臨床。
治療糖尿病
 胰島素
胰島素治療高脂血症
高脂血症系指血漿脂質濃度超過正常高限而言。鞣酸小檗鹼能明顯地增強肝臟超氧化物歧化酶的活性,降低肝臟過氧化脂質水平及血清甘油三酯、總膽固醇的含量,阻止類脂質的吸收和游離脂肪酸通過黏膜上皮細胞的再脂化作用,提高機體抗氧化能力,促進脂類的分解代謝。觀察37例高脂血症患者,其中高膽固醇血症9例,單純高甘油三酯血症12例,二者均高16例;載脂蛋白A1<1.20g/L者26例,載脂蛋白B>1.14g/L者27例;男35例,女2例。治療方法:給予口服鞣酸小檗鹼0.3~0.4g,3次/d,療程30天。觀察期間保持治療前低脂飲食,不用降脂藥物。結果:載脂蛋白A1及載脂蛋白B治療前後差異無顯著性,其餘各項差異有顯著性,25例高膽固醇血症患者,顯效20例(80%),有效5例(20%),總有效率100%,28例高甘油三脂血症患者,顯效21例(75%),有效7例(25%),總有效率100%。觀察期間未發現不良反應,血、尿常規,肝、腎功能未見異常。
治療消化性潰瘍
 十二指腸潰瘍
十二指腸潰瘍治療膽囊炎
用鞣酸小檗鹼治療慢性膽囊炎進行療效觀察。方法:治療組口服鞣酸小檗鹼0.2g,3次/d,共165例;對照組42例,用消炎利膽片和維生素B2,兩組療程均為30天。結果:治療組顯效76例(46.4%),有效69例(41.8%),無效20例(11.8%),總有效率88.2%;對照組顯效8例(191%),有效9例(21.4%),無效25例(59.5%),總有效率405%。治療組明顯優於對照組(P<0.01)。
治療痢疾
抗生素
抗生素參考文獻
[1]王小逸,史亦麗,曾衍鈞.小櫱鹼的研究進展[J].中國新藥雜誌,2003,12(7):523。
[2]鞣酸小檗鹼的臨床新用途--《中國藥理學通報》1990年05期。
